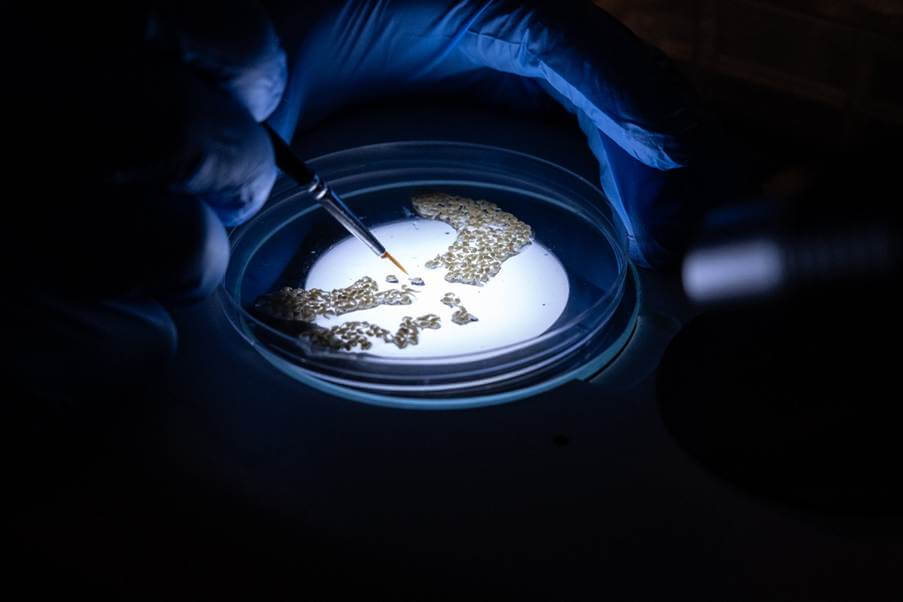

Press release
Press release – April 22, 2026
Inside the science: How malaria innovation is researched, assessed and tested

Press release – March 30, 2026
Common questions about gene drive, answered

Press release – February 23, 2026
Africa’s next generation of malaria scientists takes action

Press release – January 05, 2026
Malaria and rising child mortality put African health at a crossroads
Press release – October 17, 2025
From survivor to global malaria champion

Press release – September 11, 2025
Krystal Birungi of Target Malaria Uganda/UVRI Announced as 2025-2026 Obama Foundation Leader

Press release – August 18, 2025
Building trust, talent and technology to defeat malaria

Press release – August 14, 2025
Release of genetically modified mosquitoes: a new step in the search for innovative tools to combat malaria in Africa
